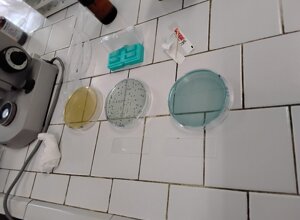
593461947_122154099668901250_4018470710037370289_n.jpeg

Loc. Staiolo - Sillicagnana - 55038 San Romano in Garfagnana (LU)
P.I. 01550040461 - Tel./Fax 0583.613154 Email garfagnanacoop@tiscali.it
Italia
.
Evento 9/11/2025
Workshop didattico sulla panificazione
Il 6 novembre 2025 si è svolto, presso l’Istituto Agrario di Castelnuovo di Garfagnana, un workshop rivolto agli studenti dedicato ai temi della panificazione e del lievito madre.
Il laboratorio ha affrontato, attraverso un approccio teorico-pratico, aspetti legati alla concimazione e alla qualità tecnologica delle granelle, ai processi di fermentazione e alla gestione degli impasti, fino all’analisi del pH e all’osservazione al microscopio delle colture microbiche.
L’attività ha permesso di mettere in relazione le conoscenze teoriche con le applicazioni pratiche della trasformazione cerealicola.

Per approfondire è possibile scaricare le slide presentate durante il workshop.
Loc. Staiolo - Sillicagnana - 55038 San Romano in Garfagnana (LU)
P.I. 01550040461 - Tel./Fax 0583.613154 Email garfagnanacoop@tiscali.it
Italia
.